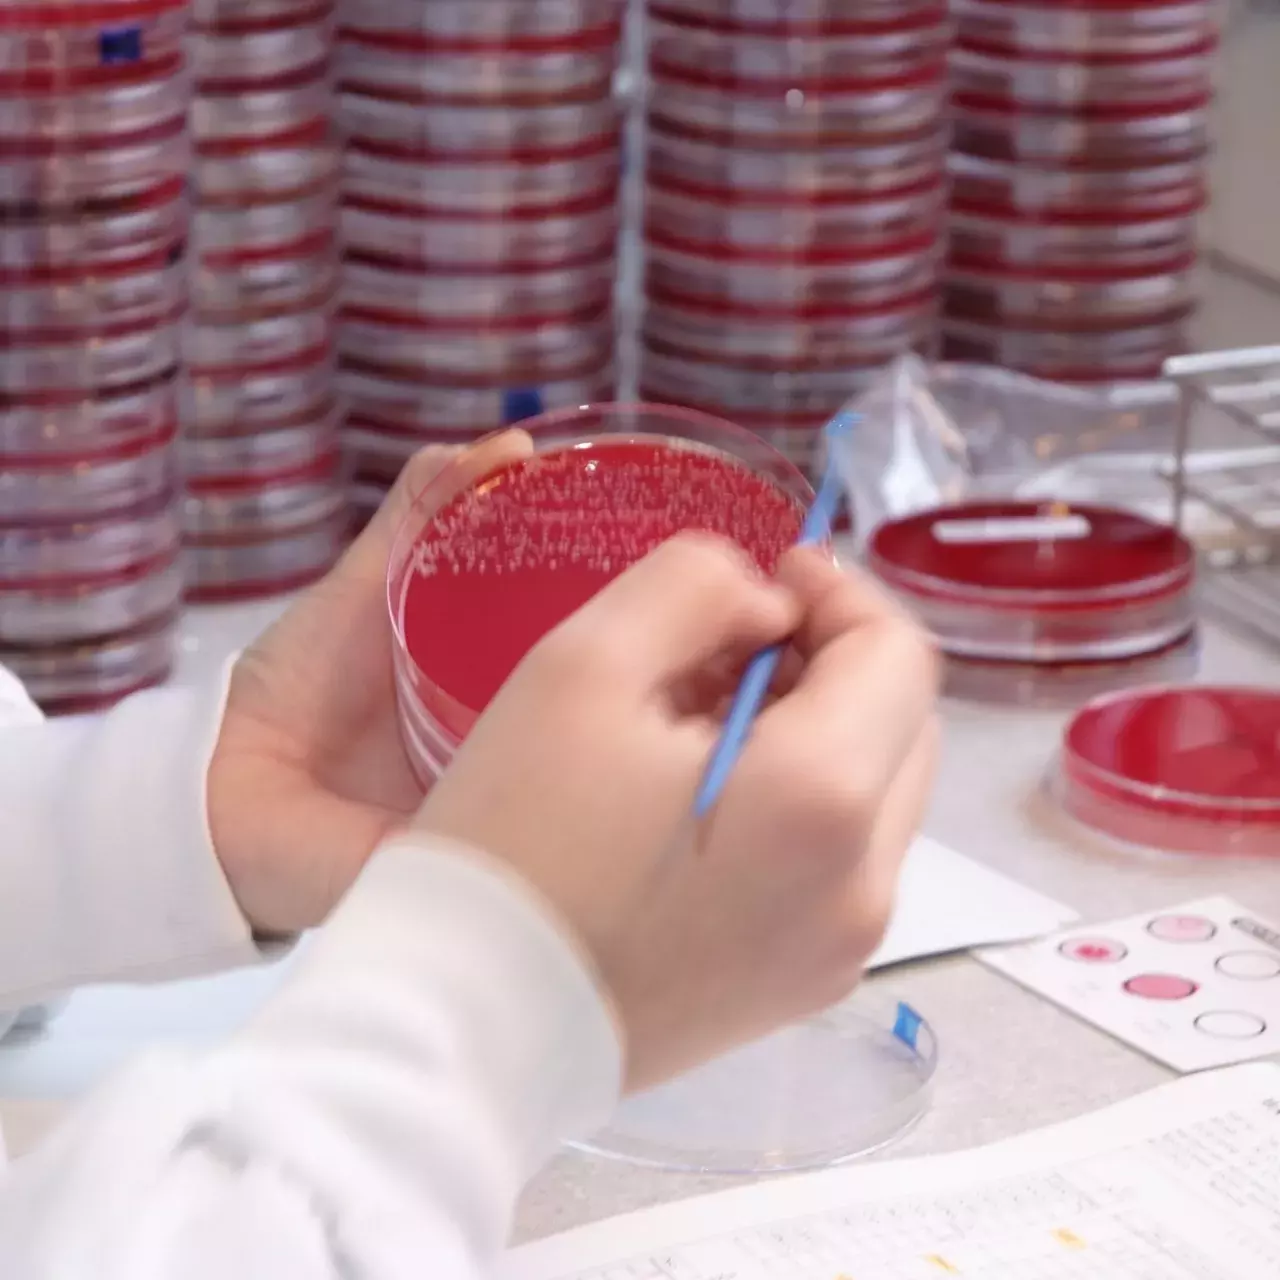
Antibio .jpg

En cas d’infection, quel antibiotique et quel dosage doivent être prescrits? Désormais, le Laboratoire de bactériologie des HUG répond à cette question et parvient à personnaliser en un temps record les traitements antibiotiques grâce à deux nouvelles chaînes d’automation.
L’utilisation de cette nouvelle technologie offre de nombreux avantages. Elle permet de raccourcir la durée des analyses d’une journée en moyenne, tout en assurant une qualité et une traçabilité optimales. Il devient également possible d’adapter pour chaque patient·e le dosage et le type d’antibiotiques à prescrire.
Ces nouvelles chaînes d’automation devraient faciliter une utilisation plus raisonnée et personnalisée des antibiotiques. Cela participe à la lutte contre l’antibiorésistance.
Le Laboratoire de bactériologie des HUG développe de multiples activités diagnostiques, dans le domaine:
En 2019, il a assuré plus de 180’000 analyses.
En savoir plus :